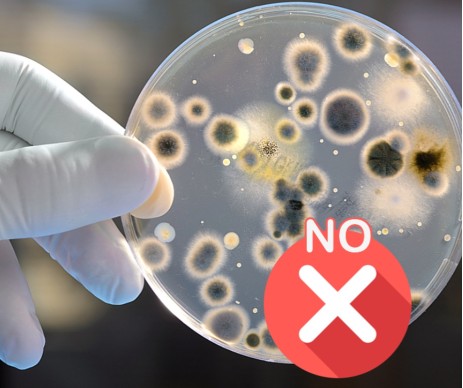
VIAMICROB VIAMICROB

VIAMICROB
- Descrizione breve: ANTIMUFFA E ANTIFILANTE
- Produttore: Eska S.r.l.
- Codice prodotto: 1005
- Codice EAN13: 8030643010052
- Confezione: Scatola da 5 Kg
- Punti premio: 23
- Disponibilità: Prodotto disponibile per la vendita on-line (vedi condizioni di vendita)
VIAMICROB è un semilavorato in polvere da aggiungere alla farina per prevenire lo sviluppo di muffe e batteri, quali l'Aspergillus flavus o niger, oppure il Penicillum glaucum, che causano l'alterazione del prodotto finito.
VIAMICROB è inoltre un ottimo batteriostatico contro la malattia del pane comunemente denominata "incordamento" o "pane filante".
VIAMICROB non altera il gusto del prodotto finito. È indicato sia per prodotti per panificazione sia per prodotti dolciari in genere.
VIAMICROB può essere utilizzato nei prodotti dolciari da forno in genere o nei seguenti tipi di panificazione:
- Pane preconfezionato in genere.
- Pane a fette preconfezionato e pane di segale.
- Pane a ridotto contenuto calorico.
- Pane semicotto preconfezionato.
- Rolls, buns e pitta preconfezionati.
DOSAGGIO: Per il pane di cui al precedente punto 1) la dose massima consigliata è di 3 grammi per ogni Kg 1 di farina (300 grammi di VIAMICROB per Kg 100 di farina), in tutti gli altri casi e per i prodotti dolciari in genere la dose è di 6 grammi per ogni Kg 1 di farina (600 grammi di VIAMICROB per Kg 100 di farina).
tag: VIAMICROB, conservante per pane, antimuffa per dolci, prevenzione muffe, panificazione sicura, batteriostatico pane, lunga conservazione